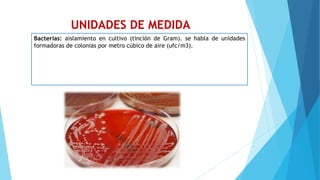
UNIDADES DE MEDIDA
Bacterias: aislamiento en cultivo (tinción de Gram). se habla de unidades
formadoras de colonias por metro cúbico de aire (ufc/m3).

Este documento trata sobre los accidentes de trabajo para el personal de salud causados por la exposición a riesgos biológicos. Define el accidente de trabajo y describe los principales agentes biológicos, las vías de transmisión, las medidas de bioseguridad para prevenir la exposición y el protocolo para atender accidentes con riesgo biológico. Clasifica los agentes patógenos según su riesgo y las áreas hospitalarias de acuerdo al nivel de riesgo.